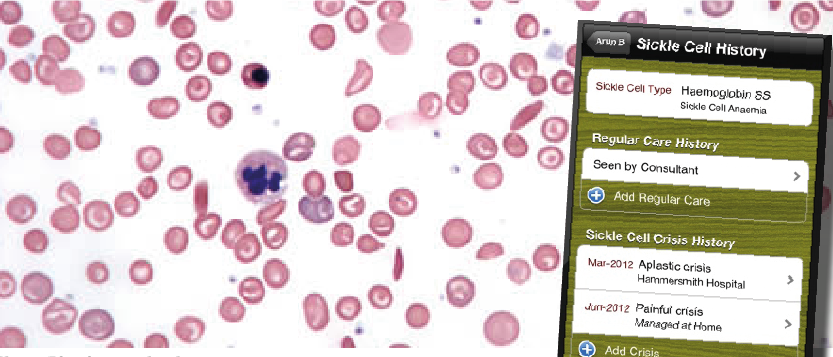
Phone app designed to aid sickle cell anaemia management

Phone app designed to aid sickle cell anaemia management
App is designed by Imperial researchers
SiKL, a new app aimed to help Sickle Cell Anaemia (SCA) Patients, has been launched by Clinicians of Imperial Health Care Trust, after collaboration with the Sickle Cell Society and participants from the TalkLab Initiative.
SiKL works as a smartphone based disease management method supplementing original paper-based medical records. SCA patients may now keep a never-out-of-space record of their conditions and actively engage in their own treatments.
As a medical record, SiKL possesses more mobility. As long as the SCA patient carries his phone, he can easily monitor medicine dosage, hydration intake, or blood tests and transfusion appointments, which can be fairly frequent for this particular disease.
Also, SiKL may act as a lifesaver. As a person always carries his phone, in times of emergency SiKL may help distinguishing his condition and treatment needed more quickly.
According to NHS figures, up to 13,500 people in UK are affected by Sickle Cell Anaemia, and in developing countries, this disease is even more prevalent. SiKL is now available globally on the app store, and has been downloaded by over 300 people.
However, Dr. Kit Huckvale from Faculty of Medicine, School of Public Health adds, “I think there probably would be work to do to develop and further refine it for particular needs and particular settings.”
Patients and their close relatives have participated in the creation of SiKL, and are now fueling its further development as well, by providing feedback and ideas such as adding medication reminders.
Patients are enabled to take on a more and more active role in their own treatment over these years, and SiKL is another tool to this end. Yet traditional medical records are not to be replaced, as Dr. Huckvale believes, “The question of how do you bridge between patients and clinicians still needs to be explored in a bit more detail.”









